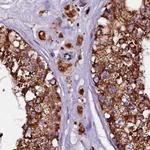
KLC2 Antibody in Immunohistochemistry (IHC)

Search
Invitrogen
KLC2 Polyclonal Antibody
{{$productOrderCtrl.translations['antibody.pdp.commerceCard.promotion.promotions']}}
{{$productOrderCtrl.translations['antibody.pdp.commerceCard.promotion.viewpromo']}}
{{$productOrderCtrl.translations['antibody.pdp.commerceCard.promotion.promocode']}}: {{promo.promoCode}} {{promo.promoTitle}} {{promo.promoDescription}}. {{$productOrderCtrl.translations['antibody.pdp.commerceCard.promotion.learnmore']}}
产品信息
PA5-59175
种属反应
宿主/亚型
分类
类型
抗原
偶联物
形式
浓度
规格
纯化类型
保存液
内含物
保存条件
运输条件
RRID
产品详细信息
Immunogen sequence: TLEDCASRNR KQGLDPASQT KVVELLKDGS GRRGDRRSSR DMAGGAGPRS ESDLEDVGPT AEWNG
Highest antigen sequence identity to the following orthologs: Mouse - 80%, Rat - 88%.
靶标信息
Modification of target proteins by ubiquitin participates in a wide array of biological functions. Proteins destined for degradation or processing via the 26 S proteasome are coupled to multiple copies of ubiquitin. However, attachment of ubiquitin or ubiquitin-related molecules may also result in changes in subcellular distribution or modification of protein activity. An additional level of ubiquitin regulation, deubiquitination, is catalyzed by proteases called deubiquitinating enzymes, which fall into four distinct families. Ubiquitin C-terminal hydrolases, ubiquitin-specific processing proteases (USPs),1 OTU-domain ubiquitin-aldehyde-binding proteins, and Jab1/Pad1/MPN-domain-containing metallo-enzymes. Among these four families, USPs represent the most widespread and represented deubiquitinating enzymes across evolution. USPs tend to release ubiquitin from a conjugated protein. They display similar catalytic domains containing conserved Cys and His boxes but divergent N-terminal and occasionally C-terminal extensions, which are thought to function in substrate recognition, subcellular localization, and protein-protein interactions.
仅用于科研。不用于诊断过程。未经明确授权不得转售。
篇参考文献 (0)
生物信息学
蛋白别名: Kinesin light chain 2; KLC 2; unnamed protein product
基因别名: KLC2
UniProt ID: (Human) Q9H0B6
Entrez Gene ID: (Human) 64837